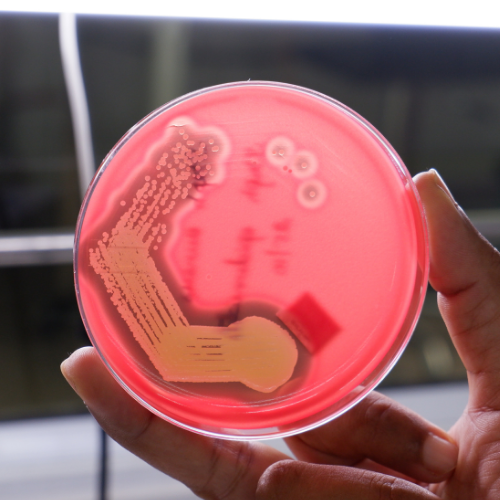
image
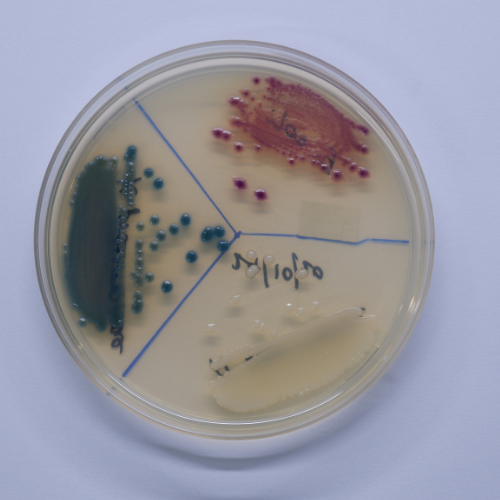
image
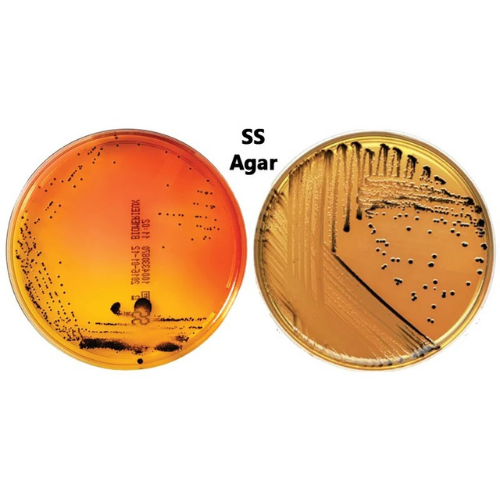
image
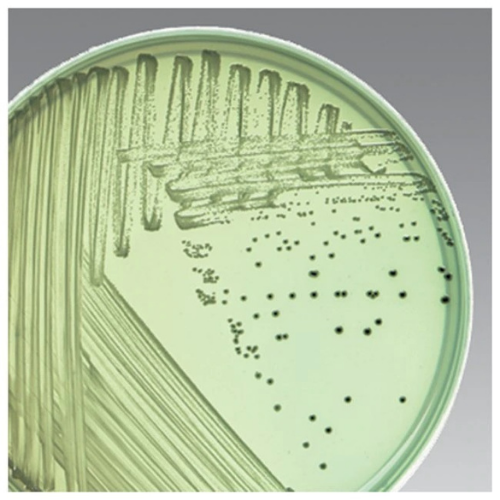
image

Ready-to-Use Media for Clinical Diagnosis
MLRS supplies high quality media (Plate and Tube) required for Clinical Diagnosis to several hospital and clinical laboratories custom-made to suit their needs.

MLRS – StatAST®
Easy-to-Perform Broth microdilution based antibiotic sensitivity testing method gives the critical antibiogram with MIC within 6-8 h much quicker than the existing automated and manual methods.